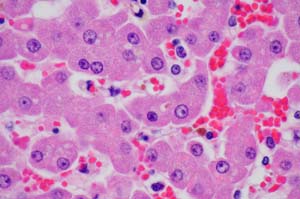

Canon EOS 40D
Performance
Review and Microscope Application
The following images and data are from initial performance evaluation on the Canon EOS 40D for general photography and photomicroscopy. I was most interested in the 40D's performance (resolution and MTF) relative to the 20D and 400D (Digital Rebel) XTi and the quality of newly-introduced features of remote capture and live preview. I also assessed autofocus and low-light focusing function.
Resolution and 50% MTF Performance
Methods
Used for Resolution and 50% MTF
Parking Garage Target - Resolution detail, noise and shadow detail
 |
 |
 |
| Full frame image EF 35mm f/1.4L lens @ f/8 ISO 100. All images shot from same location on tripod. All images processed in standard settings in Digital Photo Profesional v. 3.1 from RAW in 16 bit 300 dpi Tiff files. Files converted to 8 bit jpg's for web pages after processing. Slight unsharp mask applied to all images. Cameras at default standard tone/color settings and automatic white balance. It was raining lightly. |
Detail from Center of Frame 40D and XTi images are of similar quality and clearly superior to that produced by the 20D Canon 40D Picture Style Variations of this area |
Maximum Shadow Detail from Center of Frame The 40D has slightly better shadow detail and less noise than the XTi Same RAW image processed in DPP with +2.0 brightness. Slight (similar) auto contrast and fade autocontrast adjustment in Photoshop CS2 and same unsharp mask applied to images. |
I-75 Autofocus Test
Autofocus
speed and tracking is greatly improved with the 40D
Low Light Autofocus Test
Low
light focusing is greatly improved with the 40D compared to the 20D. As
expected, high ISO noise at ISO 1600 is reduced with the 40D.
 |
Results: EOS-1D Mark II: Focused immediately on the text in low light. EOS-40D Focused immediately on the text in low light. EOS-20D Hunted back and forth and eventually locked on the text. EOS 400D (Digital Rebel) XTi Would not focus on the text. Lens had to be manually focused. |
| My office was illuminated with a 15W fluorescent bulb bounced off the wall indirectly. Cameras were mounted on a tripod and exposures taken at f/2 with an EF 85mm f/1.8 lens and cameras set at ISO 1600. The lettering on the spine of the center book was used as a focus point with only the central focus point activated. Images were processed with DPP from RAW images and resized for the displayed photos. All images are ISO 1600 with white balance on the camera set for fluorescent light. |
40D Use in Photomicroscopy
I'm
an academic veterinary pathologist who uses light microscopic images for
diagnostic, research and teaching activities. The new features of the 40D
that were most exciting to me were the live preview and remote capture
features with high resolution image potential. Live preview allows
real-time scanning and precise focusing with a microscope
(photomicroscope). The remote capture software allows easy, intuitive
operational control for all camera functions from the computer screen with
a mouse via one USB 2 connection. Live preview sessions rapidly deplete
the battery. It is best to use a Canon AC converter with the camera.
 |
Detail of liver from a cat that died with an adverse drug reaction. Images made with 40X and 60X Nikon planapo objectives and Canon 40D camera with live preview compared to Canon 20D and Canon 400D XTi focused through angle finder. |
| Click here for microscope setup detail and screen captures of Canon software for remove capture and live preview. |
Conclusions
Other observations on improvements in the 40D over the 20D and XTi:
Index
Posted
02 September 2007; Last updated 65 September 2007
©
2007, William L. Castleman